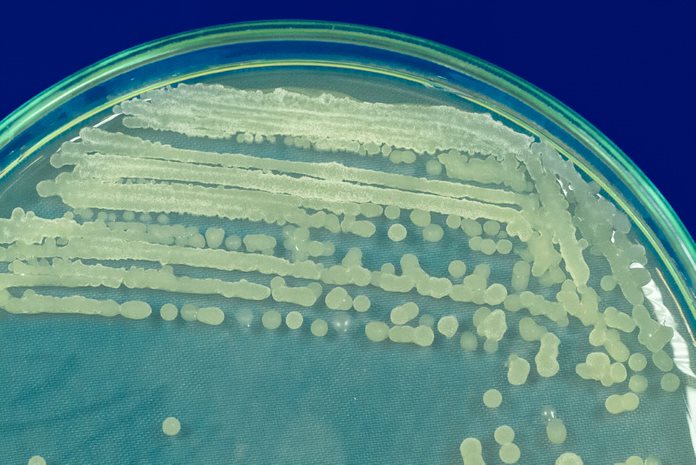

Bacilo sp. C275 (XT13)
MORFOLOGÍA
|
Tamaño colonia (mm): 2-3 Formación de ácido o álcali: N/A Tiempo de crecimiento: 24 h Color de colonia: Crema en medio CASO Transparencia: Opaca Elevación: Umbonada Forma de la colonia: Circular Borde: Redonda Formación moco: Positiva |
Imagen de “Bacillus sp”. En medio de cultivo “DYGS”. Fuente: Colección Grupo Sistemas Agropecuarios Sostenibles. AGROSAVIA.
Imagen microscópica de “Bacillus sp” de morfología bacilar Gram positiva.

Gram de “Bacillus sp “. Fuente: Colección Grupo Sistemas Agropecuarios Sostenibles. AGROSAVIA.
Asignación taxonómica ( ¿ Quién es ?)

La cepa pertenece al género Bacillus (p-value: 0.0016) y probablemente a la especie Bacillus sp. JS (p-value: 0.022).

Descripción genómica (¿Qué contiene?)
El genoma de la cepa XT13 tiene un tamaño de 4 Mpb, codificando aproximadamente 4005 proteínas, de las cuales 15 codifican para genes característicos de procesos de solubilización de fósforo, 13 para procesos de fijación de nitrógeno, 7 para producción de índoles, 41 para producción fitohormonas, 17 para actividad ACC-desaminasa y 119 de ellos pertenecen a ciclo del nitrógeno (Tu et al., 2018).
¿Qué puede hacer como biofertilizante?
Efecto de la inoculación con bacterias del género Bacillus sobre el crecimiento de Megathyrsus maximus Jacq, en condiciones de estrés hídrico VER DETALLE
Disponibilidad de nutrientes
-Fosfato de Hierro
+
-Fosfato de Aluminio
+
Potasio: Solubilización de potasio
-
Producción de sideróforos
-
Producción de hormonas de crecimiento vegetal
10,4 ± 2,3 mg AIA/mL
Producción de exopolisacáridos (EPS)
+
AGROSAVIA reconoce a Colombia como fuente y origen de información genética y/o química publicada aquí. El Estado Colombiano es titular de los recursos genéticos (incluyendo, pero sin limitarse a los recursos biológicos, recursos genéticos, datos genéticos, las secuencias digitales genéticas como expresión digital del recurso genético, genotipado, micromatrices, las proteínas virales y productos derivados), de acuerdo con lo dispuesto en el convenio de la diversidad biológica, el protocolo de Nagoya y la Decisión Andina 391. Su uso y aprovechamiento con potencial de bioprospección, aprovechamiento industrial y aprovechamiento comercial, obtenida del acceso a los recursos genéticos y sus productos derivados, se deberá previamente solicitar autorización al Ministerio de Ambiente y Desarrollo Sostenible de la Nación Colombiana.
Esta información se depositará en una base de datos de consulta, más sin embargo su uso y aprovechamiento tendrá que ser solicitado al MADS.
Cualquier inquietud por favor comuníquese al correo: recursosbiologicos@agrosavia.co







